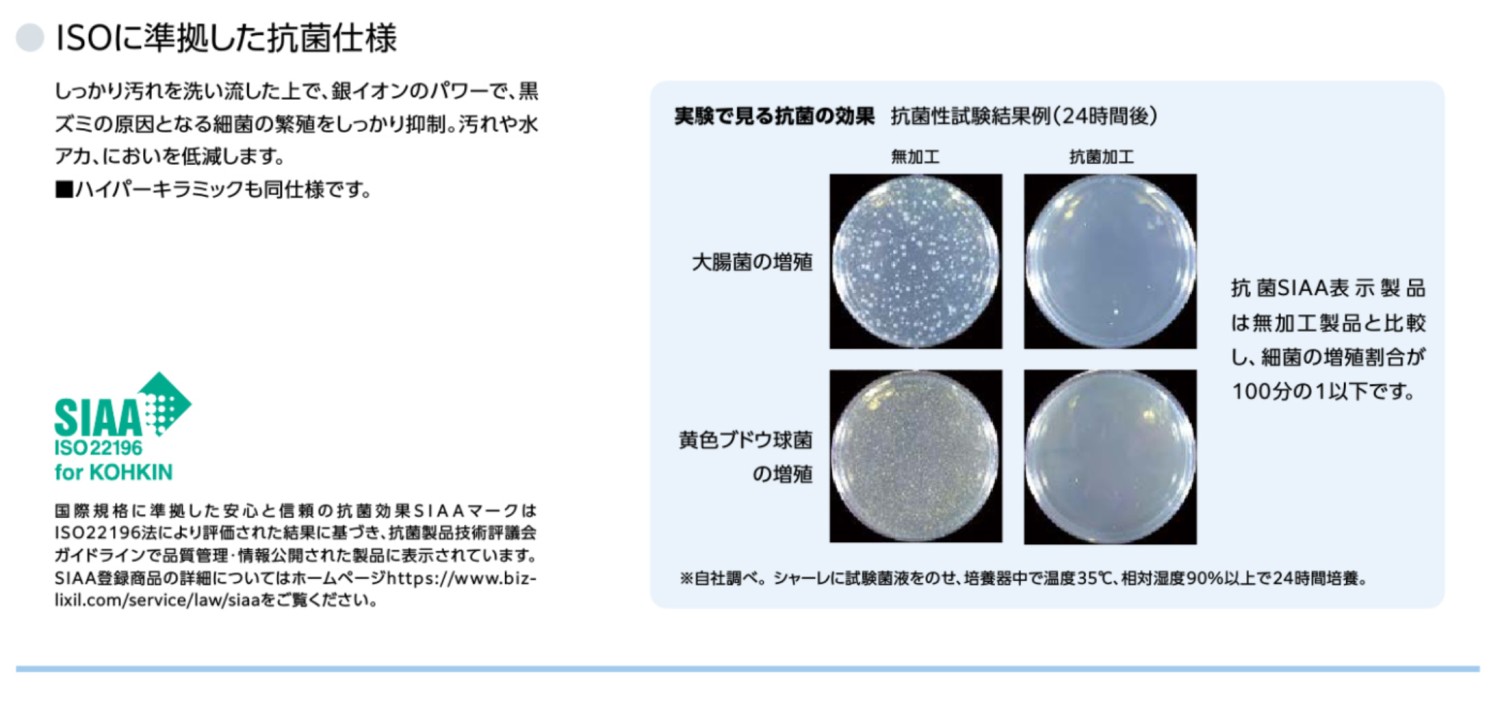

LIXIL B1 ECO5 床ベーシアシャワートイレ フチレス 一体型排水200mm 手洗無し BC-B30S_DT-B351 ホワイトBW1
58,300
LIXIL B1 ECO5 床ベーシアシャワートイレ フチレス 一体型排水200mm 手洗無し BC-B30S_DT-B351 ホワイトBW1
グレード:B1
便器部:BC-B30S
タンク部:DT-B351
カラー限定:BW1
ハイパーキラミック
排水方向:床排水
排水芯:200mm対応
手洗付
消臭機能無し
[機能]
おしり洗浄(泡ジェット洗浄)
ビデ洗浄(泡沫ソフト)
おしりワイド洗浄
おしりマッサージ洗浄
ワイドビデ洗浄
ノズル位置調節
暖房便座
スローダウン便座
着座センサー
便座ヒーターオートOFF
壁リモコン・点字対応
パワーストリーム洗浄
抗菌樹脂(ISO抗菌準拠)
便フタワンタッチ着脱
女性専用レディスノズル
ノズルオートクリーニング
スッキリノズルシャッター
ノズルそうじ
ノズル先端着脱
キレイ便座
超節水ECO5(大5L/小3.8L)/フロート弁調整時(大8L/小6L)
スーパー節電
ワンタッチ節電(8h)
電源スイッチ
グレード:B1
便器部:BC-B30S
タンク部:DT-B351
カラー限定:BW1
ハイパーキラミック
排水方向:床排水
排水芯:200mm対応
手洗付
消臭機能無し
[機能]
おしり洗浄(泡ジェット洗浄)
ビデ洗浄(泡沫ソフト)
おしりワイド洗浄
おしりマッサージ洗浄
ワイドビデ洗浄
ノズル位置調節
暖房便座
スローダウン便座
着座センサー
便座ヒーターオートOFF
壁リモコン・点字対応
パワーストリーム洗浄
抗菌樹脂(ISO抗菌準拠)
便フタワンタッチ着脱
女性専用レディスノズル
ノズルオートクリーニング
スッキリノズルシャッター
ノズルそうじ
ノズル先端着脱
キレイ便座
超節水ECO5(大5L/小3.8L)/フロート弁調整時(大8L/小6L)
スーパー節電
ワンタッチ節電(8h)
電源スイッチ